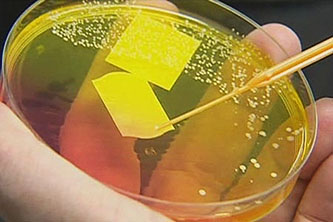

Via Austin Frakt, Aaron Kesselheim and Kevin Outterson have an op-ed in the Boston Globe about the spread of antibiotic-resistant “superbugs.” The problem, they note, is largely due to overuse of antibiotics, which spurs the evolution of the superbugs:
Via Austin Frakt, Aaron Kesselheim and Kevin Outterson have an op-ed in the Boston Globe about the spread of antibiotic-resistant “superbugs.” The problem, they note, is largely due to overuse of antibiotics, which spurs the evolution of the superbugs:
Right now, drug companies have financial incentives to maximize sales to turn a profit as quickly as they can — as soon as a new antibiotic hits the market, it’s in a race against the patent clock and competitors. To maximize profits, some companies market antibiotics for conditions that aren’t necessarily proven to respond to that treatment — like minor ear aches in children. And doctors are willing to prescribe them, especially if faced with a patient or parent who is demanding a quick fix.
….We need incentive-based policies that ensure that antibiotics are not oversold and their usefulness undermined. Under our proposal, payment for new antibiotics would be conditioned on meeting conservation and resistance targets set by the government….Instead of being subject to the traditional patent period, the manufacturer would earn revenue on the drug by showing that careful marketing and infection-control activities had slowed the rate at which resistance had developed.
I don’t have the chops to evaluate the specific plan that Kesselheim and Outterson propose. But something along these lines urgently needs to be done. There’s just one problem: it requires a considerable amount of government intervention because free markets on their own provide no incentive to care about this problem. In other words, it requires death panels. That does not bode well for the prospect of bipartisan action to do anything about this.

















